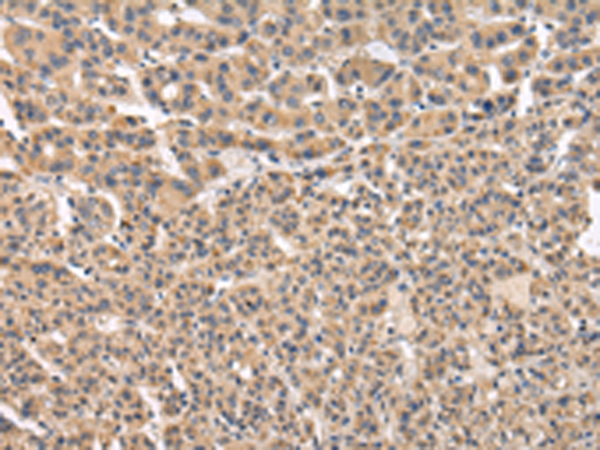

|
Background: |
Vesicle mediated protein sorting plays an important role in segregation of intracellular molecules into distinct organelles. Genetic studies in yeast have identified more than 40 vacuolar protein sorting (VPS) genes involved in vesicle transport to vacuoles. This gene encodes the human ortholog of yeast Vps41 protein which is also conserved in Drosophila, tomato, and Arabidopsis. Expression studies in yeast and human indicate that this protein may be involved in the formation and fusion of transport vesicles from the Golgi. Several transcript variants encoding different isoforms have been described for this gene, however, the full-length nature of not all is known. |
|
Applications: |
ELISA, IHC |
|
Name of antibody: |
VPS41 |
|
Immunogen: |
Fusion protein of human VPS41 |
|
Full name: |
VPS41 subunit of HOPS complex |
|
Synonyms: |
HVPS41; HVSP41; hVps41p |
|
SwissProt: |
P49754 |
|
ELISA Recommended dilution: |
2000-5000 |
|
IHC positive control: |
Human liver cancer and Human thyroid cancer |
|
IHC Recommend dilution: |
25-100 |
購物車
購物車 幫助
幫助
 021-54845833/15800441009
021-54845833/15800441009
